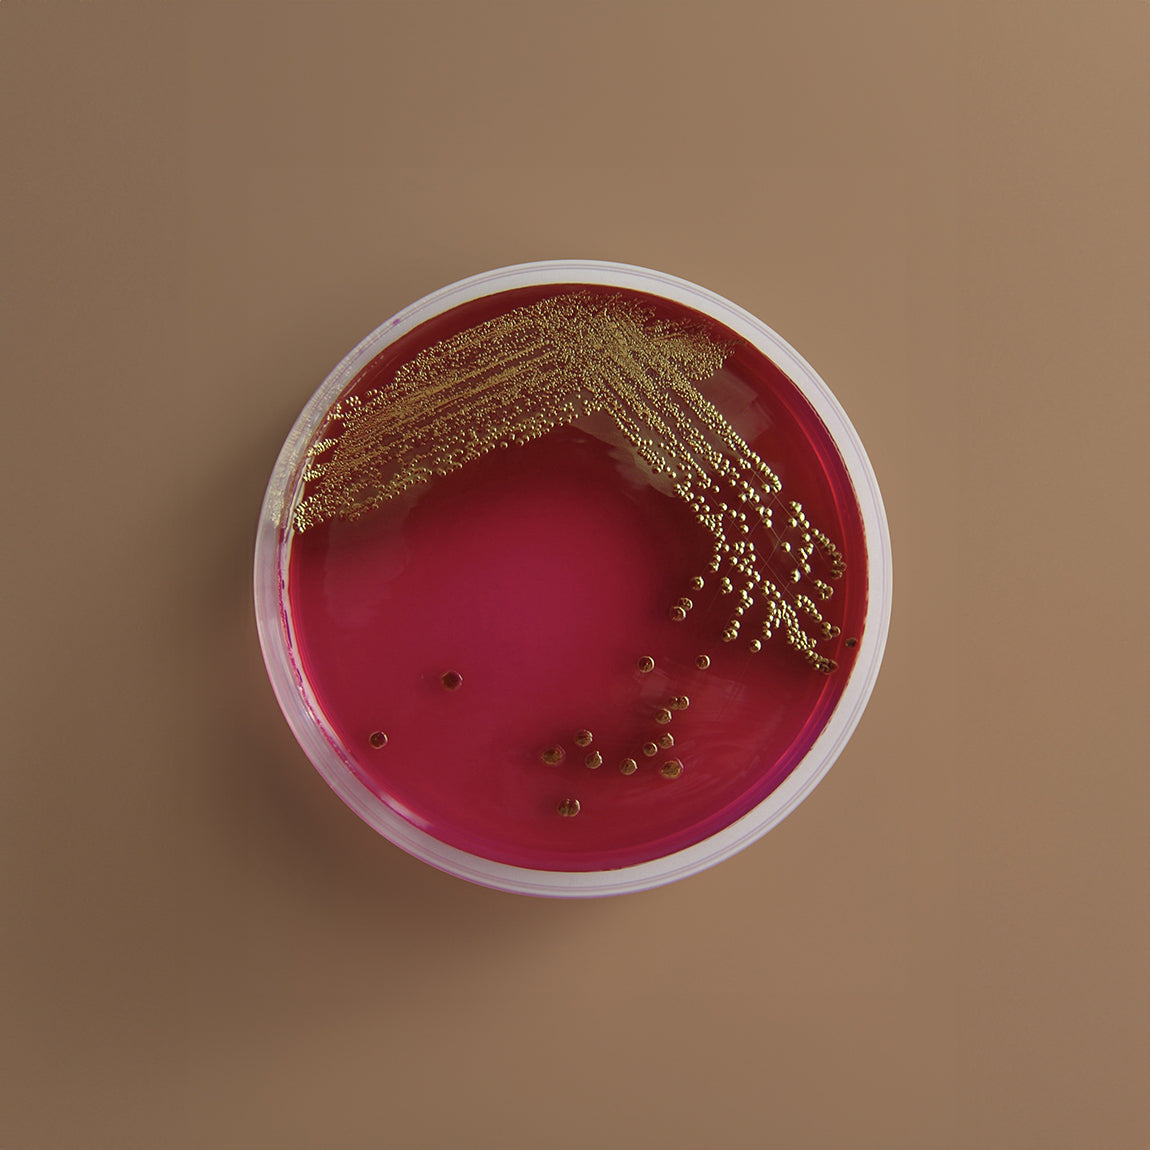
Bacterial culture plate with red agar and gold colonies on a brown background. A laboratory petri dish labeled “E. coli testing” showing visible bacterial growth, indicating a positive bacterial result.

Three-quarters of women will experience a vaginal yeast infection at some point in their lives. Yet we still treat them like shameful secrets rather than common fungal imbalances with identifiable ...

BV, yeast infections, and cytolytic vaginosis can look and feel confusingly similar—but they’re caused by completely different microbial imbalances. This guide breaks down what each one is, how to ...

We're exceptional at ignoring our own bodies until symptoms become impossible to dismiss. But what if that persistent exhaustion, those recurring headaches, or that burning sensation when you pee i...

Recurrent UTIs aren't a personal failing or a hygiene issue—they're your body's ecosystem sending an SOS. Understanding the gut-vagina-bladder connection is the first step to breaking the cycle of ...
Recurrent UTIs are often caused by biofilm—bacteria shielded from antibiotics. Learn why UTIs return and how to prevent chronic bladder infections.

BV and UTIs often get confused, but they’re completely different infections that need completely different treatments. Here’s how to spot the symptoms, avoid misdiagnosis, and protect your vaginal ...

BV and yeast infections can flare after antibiotics, sex, or even the wrong lubricant. Here’s what actually causes imbalance—and how gentle, science-backed support like UTI Biome Shield can help ke...

Your vagina is a living ecosystem. Learn how your vaginal microbiome affects UTIs, BV, fertility, immunity, and overall health—and how to keep it in balance.

Your period is more than a monthly inconvenience—it’s a vital sign. Learn what your cycle reveals about hormones, thyroid health, stress, and overall wellbeing.
Are UTI preventative antibiotics good for me?
Bacteria resistance is on the rise. 70% of UTI-causing bacteria are already resistant to antibiotics.

UTIs vs Overactive Bladder: why you're probably being misdiagnosed
Learn to distinguish between UTI and overactive bladder symptoms, causes and treatments.
UTI prevention

Recurrent UTIs are incredibly common, especially in women. Understanding your bladder microbiome and what disrupts it is the first step toward taking control of your urinary health.

Condoms don’t cause UTIs, but some can make you more vulnerable—especially if you’re already prone to infections. From spermicides to fragrances to friction, here’s what actually increases UTI risk...

Hell hath no fury like a woman who comes down with a UTI after (let's face it, probably pretty mediocre) sex.

Spoiler: If it burns when you pee, you probably already know the answer.


